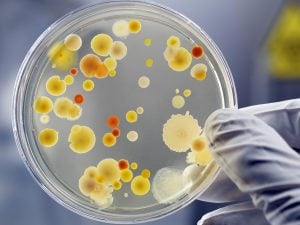

Un nuovo studio ha individuato quali sono i batteri e gli enzimi coinvolti nella sindrome dell’autoproduzione di birra, la rara condizione medica in cui il corpo produce quantità elevate etanolo anche senza il consumo di alcol.
Continua a leggere
22 Giugno 2026



